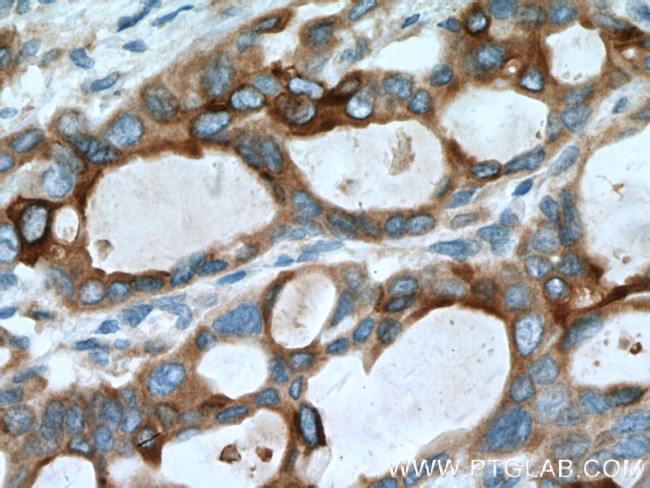
MMP7 Antibody in Immunohistochemistry (Paraffin) (IHC (P))
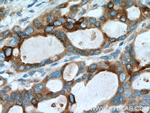
MMP7 Antibody in Immunohistochemistry (Paraffin) (IHC (P))
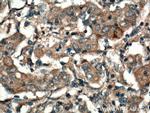
MMP7 Antibody in Immunohistochemistry (Paraffin) (IHC (P))

Search
Proteintech
MMP7 Polyclonal Antibody
{{$productOrderCtrl.translations['antibody.pdp.commerceCard.promotion.promotions']}}
{{$productOrderCtrl.translations['antibody.pdp.commerceCard.promotion.viewpromo']}}
{{$productOrderCtrl.translations['antibody.pdp.commerceCard.promotion.promocode']}}: {{promo.promoCode}} {{promo.promoTitle}} {{promo.promoDescription}}. {{$productOrderCtrl.translations['antibody.pdp.commerceCard.promotion.learnmore']}}
产品信息
10374-2-AP
种属反应
已发表种属
宿主/亚型
分类
类型
抗原
偶联物
形式
浓度
规格
纯化类型
保存液
内含物
保存条件
运输条件
产品详细信息
Immunogen sequence: MRLTVLCAV CLLPGSLALP LPQEAGGMSE LQWEQAQDYL KRFYLYDSET KNANSLEAKL KEMQKFFGLP ITGMLNSHVI EIMQKPRCGV PDVAEYSLFP N (1-100 aa encoded by BC003635)
靶标信息
Proteins of the matrix metalloproteinase (MMP) family are involved in the breakdown of extracellular matrix in normal physiological processes, such as embryonic development, reproduction, and tissue remodeling, as well as in disease processes, such as arthritis and metastasis. Most MMP's are secreted as inactive proproteins which are activated when cleaved by extracellular proteinases. The enzyme encoded by this gene degrades proteoglycans, fibronectin, elastin and casein and differs from most MMP family members in that it lacks a conserved C-terminal protein domain. The enzyme is involved in wound healing, and studies in mice suggest that it regulates the activity of defensins in intestinal mucosa. The gene is part of a cluster of MMP genes which localize to chromosome 11q22. 3.
仅用于科研。不用于诊断过程。未经明确授权不得转售。
生物信息学
蛋白别名: HGNC:7174; Matrilysin; matrilysin, uterine; Matrin; matrix metallo protease; matrix metallopeptidase 7 (matrilysin, uterine); matrix metalloproteinase 7; matrix metalloproteinase 7 (matrilysin, uterine); Matrix metalloproteinase-7; MMP; MMP 7; MMP-7; MMPs; PUMP 1; Pump 1 protease; Pump-1 protease; unnamed protein product; uterine matrilysin; Uterine metalloproteinase
基因别名: MAT; MMP-7; MMP7; MPSL1; PUMP-1; PUMP1
UniProt ID: (Human) P09237, (Mouse) Q10738
Entrez Gene ID: (Human) 4316, (Mouse) 17393